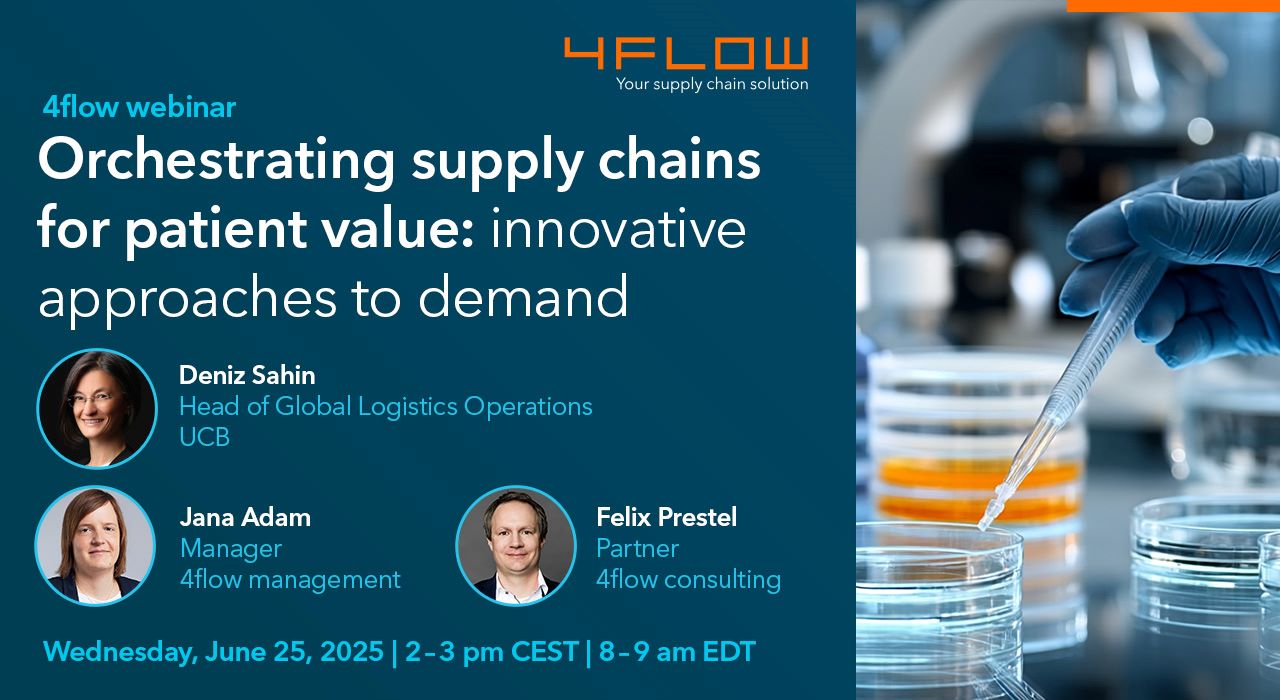

- Insights & events
- Upcoming webinars
Webinar
Supply chain orchestration for patient value: innovative demand fulfillment
Explore cutting-edge strategies and solutions that enhance supply chain efficiency and ultimately improve patient outcomes.
Together with UCB, we'll delve into supply chain orchestration to drive value with demand fulfillment. Explore cutting-edge strategies and solutions that enhance supply chain efficiency and ultimately improve patient outcomes. Don't miss this chance to gain valuable insights from industry leaders and connect with peers who are equally passionate about advancing healthcare supply chains. Let's innovate together for a healthier future!
What you can expect:
- A closer look at the supply chain orchestration journey
- Advanced strategies to improve supply chain performance
- Exclusive insights into UCB’s innovative approach to demand fulfillment